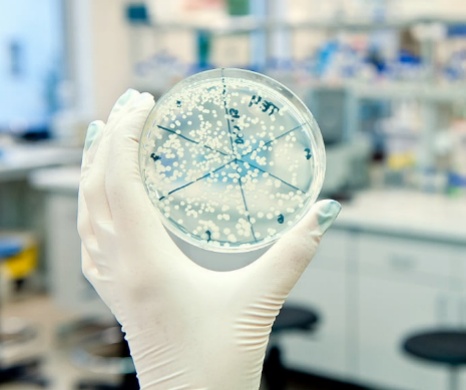

卷纸和抽纸到底有何不同,真的是用错了吗?

从表面上看,卷纸和抽纸只是纸张形态不同。但作为工业产品,卷纸和抽纸都是企业严格按照相关标准生产出来的,所以要想深入了解它们的区别,就需要查阅背后的生产标准。
市场上卷纸普遍依据的标准是GB/T 20810-2018《卫生纸(含卫生纸原纸)》(下文简称“卷纸标准”),而抽纸大多是GB/T 20808-2022《纸巾》(下文简称“抽纸标准”)。
大家对标准的名称可能不太熟悉,在这里简要介绍一下:
标准中的“GB”是“国标”的拼音首字母, 即“国家标准”的意思;
“T”是“推”的拼音首字母,即“推荐”的意思;
“20810”和“20808”是标准的顺序编号;
最后的“2018”和“2022”是标准的发布年份,标准一般也会不定期更新。
大家没有看错,这两份标准都是推荐性国家标准,并不是强制性的。
不过国有国法,行有行规,出于审批、销售等多方面的考虑,生产厂家普遍会遵循这些标准,在最后的产品上也会予以注明。这些标准都是公开发布的,大家如果感兴趣可以自行查阅。

△卷纸(左)和抽纸(右)产品上的标准说明
1设计用途不同
或许有些出乎大家的意料,其实卷纸标准在第一章就明确指出适用对象是厕用卫生纸,还规定这种纸的包装上应标注“厕用”字样,如下图所示。
不过因为标注字样太小,可能很多人都没有注意过。

△卷纸产品上的“厕用”说明
相比之下,抽纸标准的第一章则写明了适用对象是餐巾纸和手帕纸等,从这些表述也可以看出,卷纸被设计出来的初衷就是为了厕用,而抽纸才是“一心一意”地扮演着餐巾纸的角色。
2造纸原料要求不同
谈到造纸术想必大家都不陌生,它是我国伟大的四大发明之一,对人类文明的进程产生了极其深远的影响。东汉时期蔡伦改进了造纸术,用树皮、麻头及敝布等原料造纸,物美价廉,大大促进了纸的传播与使用。
其实直到今天,常用的造纸原料(纸浆)和古人的也差别不大,分类如下图所示。利用纸浆中的纤维,造出有强度有韧性的纸张。

一般认为原生木浆质量最好,原生非木浆次之,而回用浆的质量最差。卷纸标准允许用原生浆或回用浆,原生浆卷纸按质量可分为优等品、一等品和合格品(优等品最好,合格品最次);而抽纸标准则要求必须为原生浆,普通型可分为优等品和合格品。
不过大家看到这里不用太担心,在实际商品中,多数品牌卷纸的原料均注明为“100%原生木浆”,质量应该是有保障的。此外近来还有商家宣传纯木浆,在这里需要提醒大家,纯木浆和原生木浆不同,原生木浆是从天然木材而来,而纯木浆可能包括回收的二手木浆。

△ 卷纸和抽纸的商品纸浆和质量说明
3微生物要求不同
生产标准上,卷纸的细菌菌落总数不得超过600CFU/g,而抽纸不得超过200 CFU/g。CFU是“菌落形成单位(colony-forming unit)”的意思,“600”和“200”可以理解为培养皿上的菌落数量。
看到这里有读者可能有疑问,“细菌菌落总数”听着有点奇怪,为什么不用“细菌数量”呢?其实倒也不是研究人员不想用,主要是细菌实在太小太多了,不可能通过肉眼一个一个数清楚,这也让研究人员犯了难。
后来有人想到细菌生长时往往以自己为中心发展成一个聚落,每一个聚落都表示这里一开始至少有一个细菌,所以就用培养一段时间后的菌落数量来表征一开始细菌的数量了。
若将纸的密度以0.5g/cm3计算,对于一节卷纸,假设长度为16cm,宽度为12cm,厚度为0.025cm,则重量为16×12×0.025×0.5=2.4g,细菌菌落总数不超过1440CFU;对于一张抽纸,假设长度为20cm,宽度为16cm,厚度为0.025cm,则重量为20×16×0.025×0.5=4g,细菌菌落总数不超过800CFU。
考虑到单节卷纸的面积一般比单张抽纸小,卷纸的用量往往会更多,故实际生活中二者的细菌数量差异会更大。当然不同纸的大小厚度各不相同,这个估算仅供参考,具体以检测为准。

卷纸和抽纸对比 图片来源:作者拍摄
从数量上看,抽纸确实更卫生一些,不过到底卫生了多少,可能大家也缺乏一个具体的概念。我们以每个人都非常熟悉的手和手机为例做个说明。2015年成都市第三人民医院在“全球洗手日”走进写字楼开展细菌检测公益项目,结果发现职场人士一只手洗手前的细菌菌落总数可达500CFU。
数字或许还不够有冲击力,下面放张图,是美国生物学家Tasha Sturm让刚从外面玩耍回来的儿子在培养皿上摁手印后培养出来的结果,触目惊心。
不过值得一提的是,洗手可以有效降低手上的细菌数量,成都三院在前文提到的活动中发现职场人士洗手后细菌菌落总数可降至5CFU以下。

英国《每日邮报》2018年8月报道手机屏幕是藏污纳垢的重灾区,在手机保险公司Insurance2go的调查样本中,三星Galaxy8每平方厘米屏幕的细菌菌落总数有100CFU,iPhone 6有40CFU,谷歌Pixel有12CFU。我们以位处中间的iPhone 6为例计算一下,iPhone 6高138.1mm,宽67.0mm,正面面积92.527cm2。
考虑到不是全面屏设计,将屏幕面积折减到80cm2,那么iPhone 6屏幕上总共有40×80=3200 CFU,这还不包括手机背面等其他区域。在这里建议大家定期清洁手机,就餐时也最好放下恋恋不舍的手机,毕竟小别是为了更好的相聚。

比较下来,如果卷纸和抽纸都刚好达到标准,那么一节卷纸和一张抽纸的细菌数量差距大概相当于一只手上的细菌数量,或者1/5手机屏幕上的细菌数量。
4技术指标不同
卷纸和抽纸的技术指标有多项不同,其中比较受关注的是可迁移性荧光物质、重金属含量和纵向湿抗张强度。
“可迁移性”是指物质能通过碰触转移到皮肤或粘膜上;“荧光物质”主要指生产厂家为了让纸巾显得更白而使用的荧光增白剂,它是一种复杂的有机化合物,进入体内后可能造成危害。
人体皮肤表面有角质层,可以阻碍皮肤吸收像荧光增白剂这样的大分子有机物,但当我们用纸巾擦嘴时,如果纸中存在可迁移的荧光增白剂,它就有可能进入口中造成健康隐患。
在生产标准中,对抽纸和使用原生浆的卷纸均已明确要求不得在纸面上检测出可迁移性荧光物质,但对使用回用浆的卷纸未作要求,存在安全隐患。
在重金属含量上,抽纸检测的元素种类比卷纸多,标准也更严格,如下表所示:

出于用途需求,抽纸要求纸巾有较高的纵向湿抗张强度,使用时遇水后仍然比较强韧,不会到处沾上纸屑,方便擦拭嘴巴、餐桌等;而卷纸则要求较低的纵向湿抗张强度,上厕所使用后遇水快速分散,避免堵塞下水道。
我们可以做个简单实验证实一下,如图所示,分别将一节卷纸和一张抽纸放入同样的水杯中,搅拌相同时间后,卷纸被撕裂分散开来,杯中水变得浑浊;而抽纸仍然保持完整,杯中水也比较清澈。大家如果有兴趣也可以自己试试。

回到一开始的问题:卷纸到底能不能用来擦嘴呢?其实通过前面的分析我们可以看到,卷纸的各项指标都是围绕着厕用设计的,如果条件允许的话,还是建议专纸专用,餐巾纸用抽纸,厕用纸用卷纸。
当然了,因为大部分品牌卷纸的质量都比较好,如果身上没有带抽纸,事急从权,临时用质量好的卷纸当餐巾纸也没有什么问题。就像香皂和肥皂,如果香皂正好用完了,偶尔也能用肥皂洗洗手。不过若是遇到街边小餐馆或者公共卫生间等提供的质量不明的卷纸时,建议还是小心为上,不要用来擦嘴。
最后需要提醒大家的是,无论是卷纸还是抽纸,都是有保质期的,一般为3年,在包装上也有注明。过了保质期后,纸的微生物数量可能已经超过适用范围,强度和韧性也不再有保障,此时不建议大家再继续使用这些纸,至少不要用来擦拭皮肤(可以用来清洁桌子柜子等),以守护我们的身体健康。
资料:科普中国